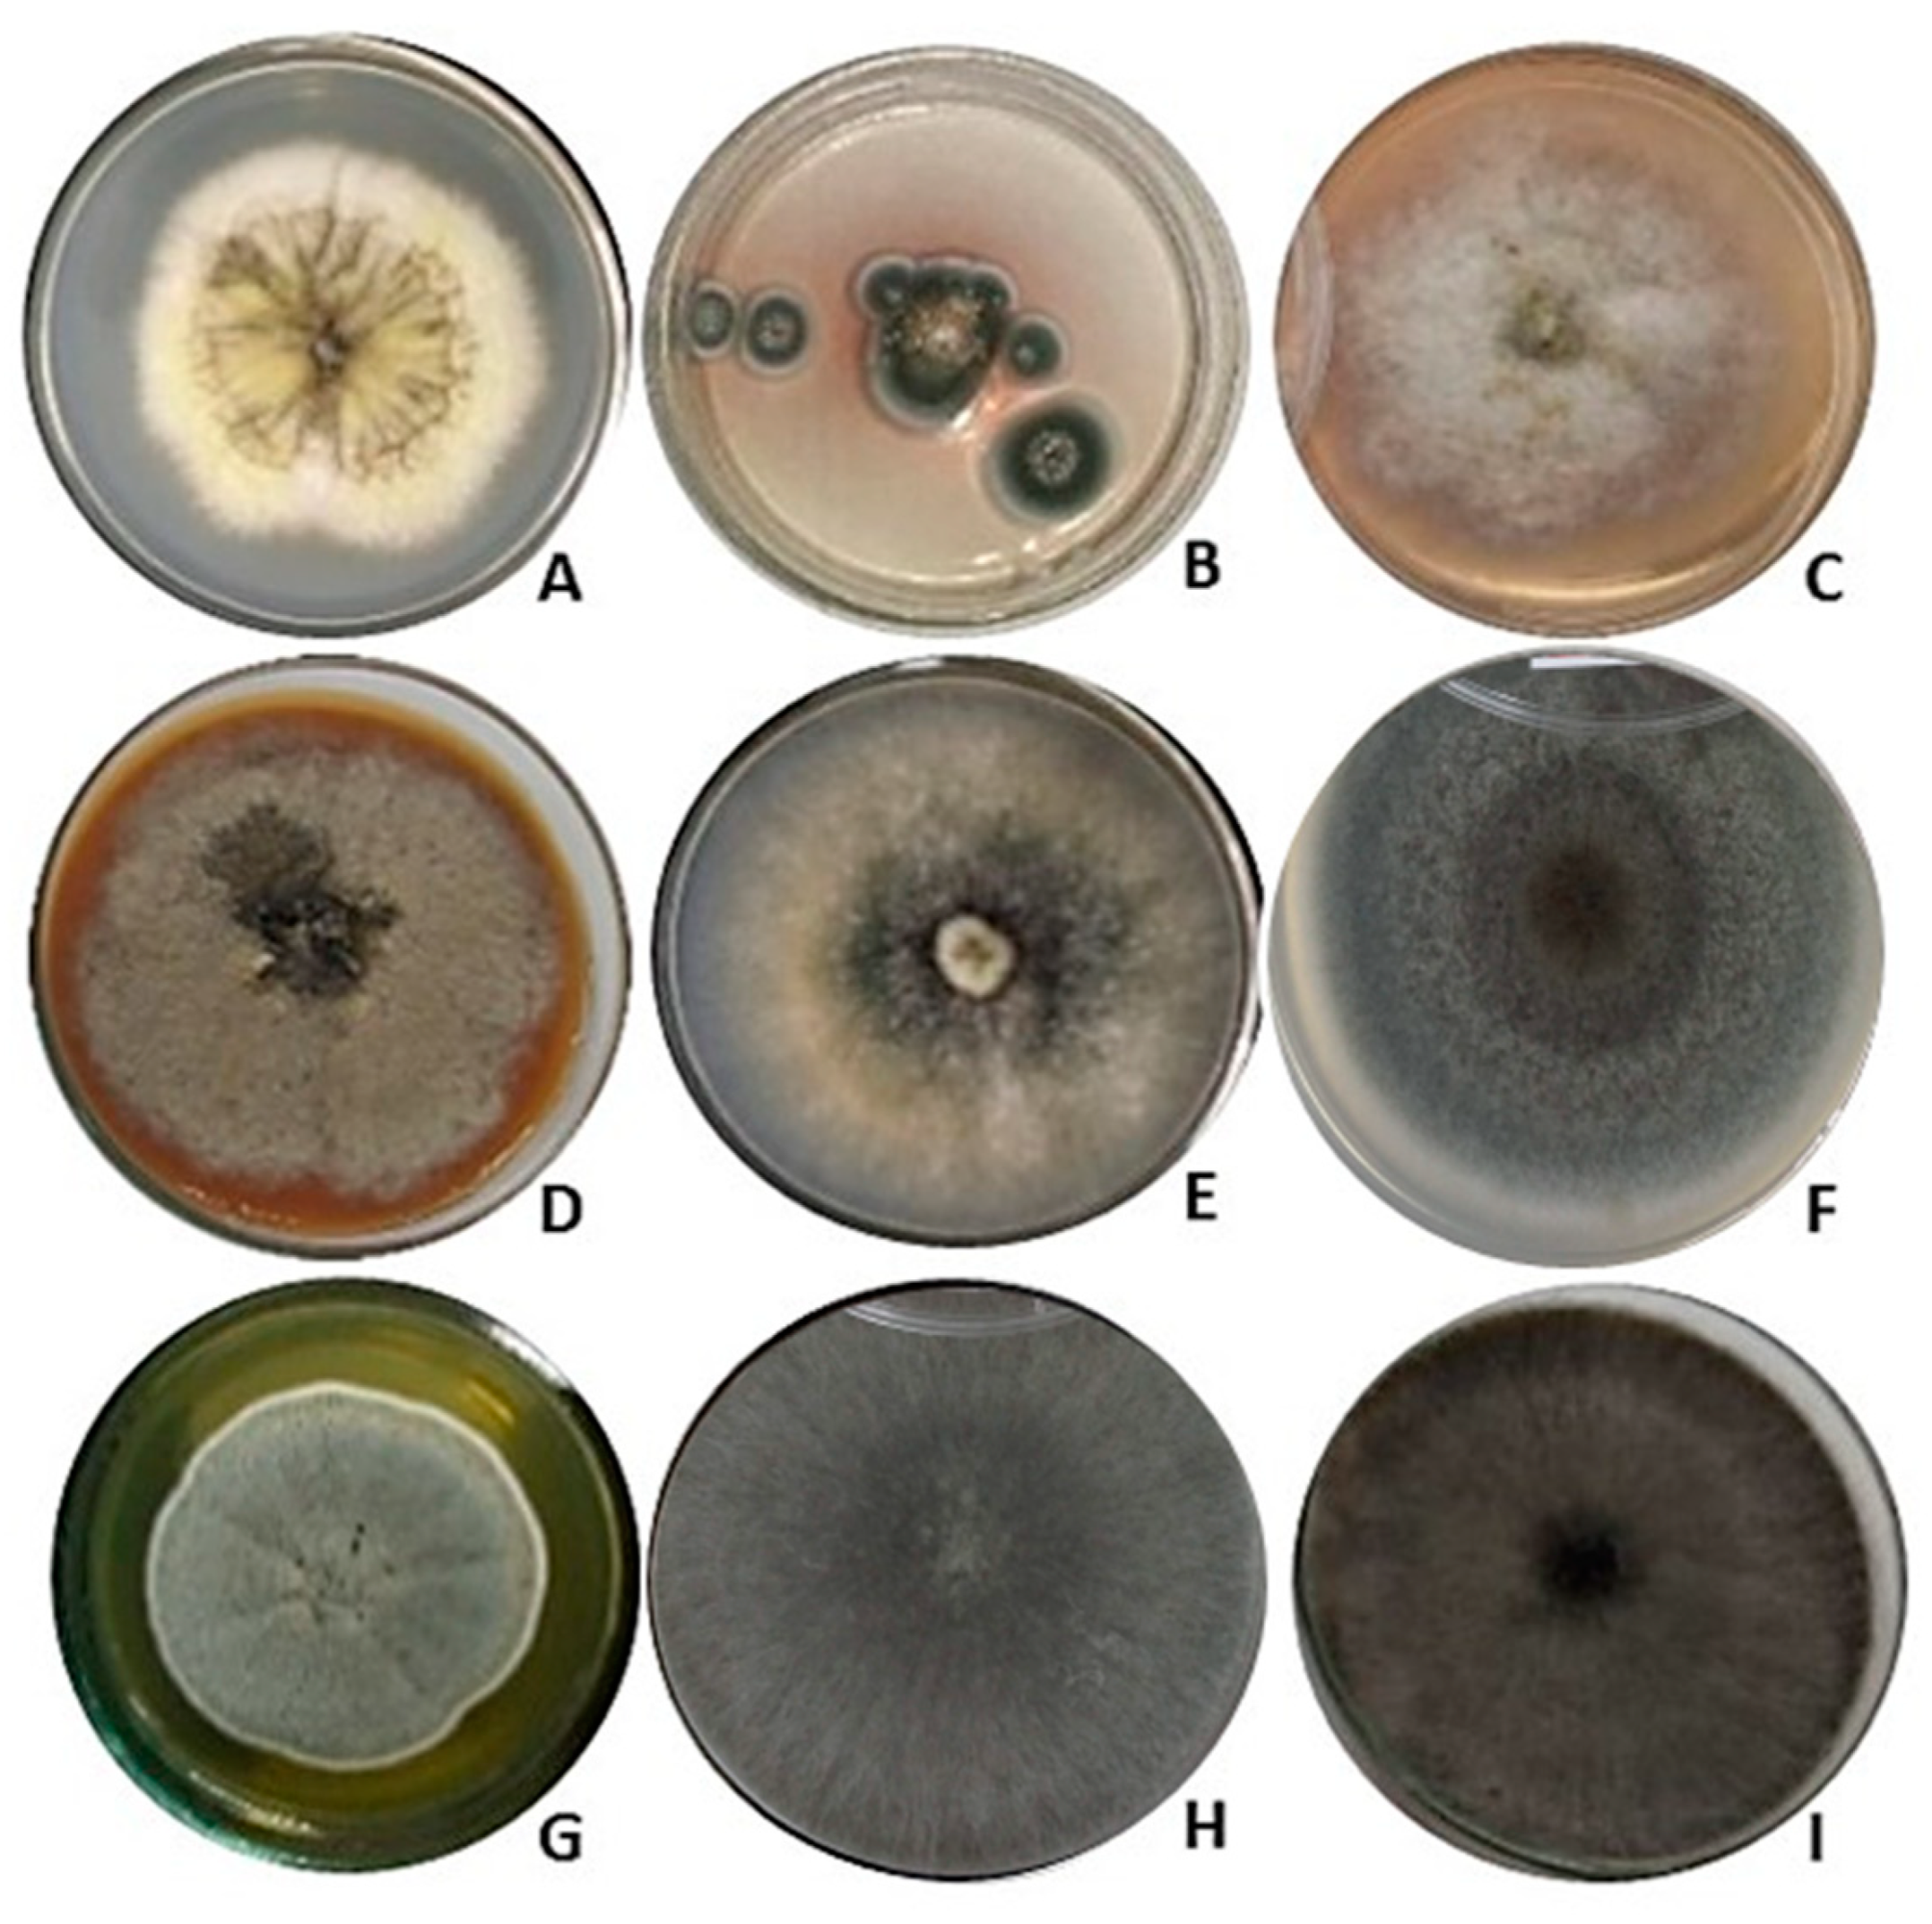
Jof 10 00077 g001

Isolation and Identification of Pigment-Producing Endophytic Fungi from the Amazonian Species Fridericia chica
Abstract
1. Introduction
2. Materials and Methods
2.1. Collection of Plant Material
2.2. Isolation of Endophytic Fungi
2.3. Selection of Pigment-Producing Fungi in a Solid Medium
2.4. Pigment Production in Submerged Fermentation
2.5. Extraction of Pigments from the Culture Medium
2.6. Evaluation of the Biological Activities of the Promising Pigmented Extract
2.7. Chemical Profile of the Active Pigmented Extract
2.8. Molecular Identification of Pigment-Producing Endophytic Fungi from Fridericia chica
2.9. Phylogenetic Analysis
3. Results
3.1. Selection of Pigment-Producing Endophytic Fungi from Fridericia chica
3.2. Pigment Production Using Submerged Fermentation
3.3. Phylogenetic Analysis of Pigment-Producing Endophytic Fungi from Fridericia chica
3.4. Biological Activities of the Most-Promising Pigmented Extract
3.5. Chemical Profile of the Most-Promising Pigmented Extract
4. Discussion
5. Conclusions
Supplementary Materials
Author Contributions
Funding
Institutional Review Board Statement
Informed Consent Statement
Data Availability Statement
Acknowledgments
Conflicts of Interest
References
- Dhyani, A.; Jain, R.; Pandey, A. Contribution of root-associated microbial communities on soil quality of oak and pine forests in the Himalayan ecosystem. Trop. Eco. 2019, 60, 271–280. [Google Scholar] [CrossRef]
- Bacon, C.W.; White, J.F. Microbial Endophytes; Marcel Dekker: New York, NY, USA, 2000; pp. 3–29. [Google Scholar]
- Rathod, D.; Dar, M.G.A.; Shrivastava, R.B.; Rai, M.; Varma, A. Microbial Endophytes: Progress and Challenges. In Biotechnology for Medicinal Plants; Chandra, S., Lata, H., Varma, A., Eds.; Springer: Berlin/Heidelberg, Germany, 2013; pp. 101–121. [Google Scholar] [CrossRef]
- Hamilton, C.E.; Bauerle, T.L. A new currency for mutualism? Fungal endophytes alter antioxidant activity in hosts responding to drought. Fungal Div. 2012, 54, 39–49. [Google Scholar] [CrossRef]
- Fadiji, A.E.; Babalola, O.O. Elucidating mechanisms of endophytes used in plant protection and other bioactivities with multifunctional prospects. Front. Bioeng. Biotechnol. 2020, 8, 467. [Google Scholar] [CrossRef] [PubMed]
- Balkrishna, A.; Joshi, R.; Arya, A.D.V. Endophytic fungi: A Comprehensive Review on Their Secondary Metabolites, Pharmacological Interventions and Host Plant Interactions. In Endophytic Fungi: Biodiversity, Antimicrobial Activity and Ecological Implications; Wu, Q.-S., Zou, Y.-N., Xu, Y.-J., Eds.; Nova Science Publishers: New York, NY, USA, 2022; pp. 1–62. [Google Scholar]
- Strobel, G. The emergence of endophytic microbes and their biological promise. J. Fungi 2018, 4, 57. [Google Scholar] [CrossRef] [PubMed]
- Gurgel, R.S.; Pereira, D.Í.M.; Garcia, A.V.F.; Souza, A.T.F.; Silva, T.M.; Andrade, C.P.; Silva, W.L.; Nunez, C.V.; Fantin, C.; Procópio, R.E.L.; et al. Antimicrobial and antioxidant activities of endophytic fungi associated with Arrabidaea chica (Bignoniaceae). J. Fungi 2023, 9, 864. [Google Scholar] [CrossRef]
- Pamphile, J.A.; Costa, A.T.; Rosseto, P.; Polonio, J.C.; Pereira, J.O.; Azevedo, J.L. Biotechnological applications of secondary metabolites extracted from endophytic fungi: The case of Colletotrichum sp. Rev. UNINGÁ 2017, 53, 113–119. [Google Scholar]
- Sen, T.; Barrow, C.J.; Deshmukh, S.K. Microbial pigments in the food industry—Challenges and the way forward. Front. Nutr. 2019, 6, 7. [Google Scholar] [CrossRef]
- Anugraha, A.C.; Thomas, T. A review on pigment producing soil fungi and its applications. Asian J. Mycol. 2021, 4, 89–112. [Google Scholar]
- Mapari, S.A.S.; Nielsen, K.F.; Larsen, T.O.; Frisvad, J.C.; Meyer, A.S.; Thrane, U. Exploring fungal biodiversity for the production of water-soluble pigments as potential natural food colorants. Curr. Opin. Biotechnol. 2005, 16, 231–238. [Google Scholar] [CrossRef]
- Mukherjee, G.; Mishra, T.; Deshmukh, S.K. Fungal Pigments: An Overview. In Developments in Fungal Biology and Applied Mycology; Satyanarayana, T., Deshmukh, S., Johri, B., Eds.; Springer: Singapore, 2017; pp. 525–541. [Google Scholar] [CrossRef]
- Dufosse, L.; Fouillaud, M.; Caro, Y.; Mapari, S.A.; Sutthiwong, N. Filamentous fungi are large-scale producers of pigments and colorants for the food industry. Curr. Opin. Biotechnol. 2014, 26, 56–61. [Google Scholar] [CrossRef]
- Gentry, A.H. Bignoniaceae. Flora de Colombia no. 25; Instituto de Ciencias Naturales, Universidad Nacional de Colombia: Bogotá, Colombia, 2009; 462p. [Google Scholar]
- Cronquist, A. An Integrated System of Classification of Flowering Plants; Columbia University Press: New York, NY, USA, 1981; pp. 248–250. [Google Scholar]
- Batalha, A.D.d.S.J.; Souza, D.C.d.M.; Ubiera, R.D.; Chaves, F.C.M.; Monteiro, W.M.; da Silva, F.M.A.; Koolen, H.H.F.; Boechat, A.L.; Sartim, M.A. Therapeutic potential of leaves from Fridericia chica (Bonpl.) L. G. Lohmann: Botanical aspects, phytochemical and biological, anti-inflammatory, antioxidant and healing action. Biomolecules 2022, 12, 1208. [Google Scholar] [CrossRef]
- Schiozer, A.L.; Cabral, E.C.; Godoy, L.A.F.; Chaves, F.C.M.; Poppi, R.J.; Riveros, J.M.; Eberlinb, M.N.; Barata, L.E.S. Electrospray ionization mass spectrometry fingerprinting of extracts of the leaves of Arrabidaea chica. J. Braz. Chem. Soc. 2012, 23, 409–414. [Google Scholar] [CrossRef]
- Amaral, R.R.; Santos, A.A.D.; Saravia, A.; Botas, G. Biological activities of Arrabidaea chica (Bonpl.) B. Verl. leaves. Lat. Am. J. Pharm. 2012, 31, 451–455. [Google Scholar]
- Siraichi, J.T.G.; Felipe, D.F.; Brambilla, L.Z.R.; Gatto, M.J.; Terra, V.A.; Cecchini, A.L.; Cortez, L.E.R.; Rodrigues-Filho, E.; Cortez, D.A.G. Antioxidant capacity of the leaf extract obtained from Arrabidaea chica cultivated in Southern Brazil. PLoS ONE 2013, 8, 72733. [Google Scholar] [CrossRef] [PubMed]
- Taffarelo, D.; Jorge, M.P.; Sousa, I.M.d.O.; Duarte, M.C.T.; Figueira, G.M.; Queiroz, N.d.C.A.; Rodrigues, R.A.F.; Carvalho, J.E.d.; Goes, A.L.T.R.; Foglio, M.A.; et al. Activity of Arrabidaea chica (Humb. & Bonpl.) Verlot extracts obtained by biotechnological processes on fibroblast and human tumor cells. Quim. Nova 2013, 36, 431–436. [Google Scholar] [CrossRef]
- Ribeiro, F.M.; Volpato, H.; Lazarin-Bidóia, D.; Desoti, V.C.; Souza, R.O.d.; Fonseca, M.J.V.; Ueda-Nakamura, T.; Nakamura, C.V.; Silva, S.d.O. The extended production of UV-induced reactive oxygen species in L929 fibroblasts is attenuated by posttreatment with Arrabidaea chica through scavenging mechanisms. J. Photochem. Photobiol. B Biol. 2018, 178, 175–181. [Google Scholar] [CrossRef]
- Araújo, W.L.; Lima, A.O.S.; Azevedo, J.L.; Marcon, J.; Kuklinsky, S.J.; Lacava, P.T. Manual: Isolamento de Microrganismos Endofíticos; Universidade de São Paulo: Piracicaba, Brazil, 2002. [Google Scholar]
- Castellani, A. Viability of some pathogenic fungi in distilled water. J. Trop. Med. Hyg. 1939, 42, 225–226. [Google Scholar]
- Heo, Y.M.; Kim, K.; Kwon, S.L.; Na, J.; Lee, H.; Jang, S.; Kim, J.J. Investigation of filamentous fungi producing safe, functional water-soluble pigments. Mycobiol. 2018, 46, 269–277. [Google Scholar] [CrossRef]
- Bose, P.; Gowrie, S.U.; Chathurdevi, G. Optimization of culture conditions of growth and production of bioactive metabolites by endophytic fungus—Aspergillus tamarii. Int. J. Pharm. Biol. Sci. 2019, 9, 469–478. [Google Scholar] [CrossRef]
- Zanette, G.F. Pigmentos Naturais Produzidos por Fungos Filamentosos Isolados de Theobroma grandiflorum (Willd. Ex Spreng.) Schum. (cupuaçu). Ph.D. Thesis, Federal University of Amazonas, Manaus, Brazil, 2013. [Google Scholar]
- Oliveira, L.A. Produção, Isolamento e Identificação de Colorantes Produzidos por Fungos Isolados de Amostras do Solo amazônico. Master’s Thesis, Amazonas State University, Manaus, Brasil, 2017. [Google Scholar]
- Molyneux, P. The use of the stable free radical diphenylpicrylhydrazyl (DPPH) for estimating antioxidant activity. Songklanakarin. J. Sci. Technol. 2004, 26, 211–219. [Google Scholar]
- Duarte-Almeida, J.M.; Dos Santos, R.J.; Genovese, M.I.; Lajolo, F.M. Evaluation of the antioxidant activity using the β-carotene/linoleic acid system and the DPPH scavenging method. Food Sci. Technol. 2006, 26, 446–452. [Google Scholar] [CrossRef]
- Benzie, I.F.F.; Strain, J.J. The Ferric Reducing Ability of Plasma (FRAP) as a measure of “antioxidant power”: The FRAP assay. Anal. Biochem. 1996, 239, 70–76. [Google Scholar] [CrossRef] [PubMed]
- CLSI Standard M27; Reference Method for Broth Dilution Antifungal Susceptibility Testing of Yeasts. Clinical and Laboratory Standards Institute: Wayne, PA, USA, 2017.
- Lopes, J.L.C. Cromatografia em Camada Delgada. In Fundamentos de Cromatografia; Collins, C.H., Braga, G.L., Bonato, P.S., Eds.; Editora da Unicamp: Campinas, Brazil, 2006; pp. 67–86. [Google Scholar]
- Wagner, H.; Bladt, S. Plant Drug Analysis: A Thin Layer Chromatography Atlas; Springer: Munich, Germany, 1996; 384p. [Google Scholar]
- Doyle, J.; Doyle, J.L. Isolation of plant DNA from fresh tissue. Focus 1990, 12, 13–15. [Google Scholar]
- Oetari, A.; Rahmadewi, M.; Rachmania, M.K.; Sjamsuridzal, W. Molecular identification of fungal species from deteriorated old chinese manuscripts in Central Library Universitas Indonesia. AIP Conf. Proc. 2018, 2023, 020122. [Google Scholar] [CrossRef]
- White, T.J.; Bruns, T.; Lee, S.J.W.T.; Taylor, J. Amplification and direct sequencing of fungal ribosomal RNA genes for phylogenetics. In PCR Protocols: A Guide to Methods and Applications; Innis, M.A., Gelfand, D.H., Sninsky, J.J., White, T.J., Eds.; Academic Press: New York, NY, USA, 1990; pp. 315–322. [Google Scholar]
- Glass, N.L.; Donaldson, G.C. Development of primer sets designed for use with the PCR to amplify conserved genes fromfilamentous ascomycetes. Appl. Environ. Microbiol. 1995, 61, 1323–1330. [Google Scholar] [CrossRef] [PubMed]
- Carbone, I.; Kohn, L.M. A method for designing primer sets for speciation studies in filamentous ascomycetes. Mycologia 1999, 91, 553–556. [Google Scholar] [CrossRef]
- Liu, Y.J.; Whelen, S.; Hall, B.D. Phylogenetic relationships among ascomycetes: Evidence from an RNA polymerase II subunit. Mol. Biol. Evol. 1999, 16, 1799–1808. [Google Scholar] [CrossRef] [PubMed]
- Hall, T.A. BioEdit: A user-friendly biological sequence alignment editor and analysis, program for Windows 95/98/NT. Nucleic Acids Symp. Ser. 1999, 41, 95–98. [Google Scholar] [CrossRef]
- Katoh, K.; Rozewicki, J.; Yamada, K.D. MAFFT online service: Multiple sequence alignment, interactive sequence choice and visualization. Brief. Bioinform. 2019, 20, 1160–1166. [Google Scholar] [CrossRef]
- Kumar, S.; Stecher, G.; Li, M.; Knyaz, C.; Tamura, K. Mega X: Molecular Evolutionary Genetics Analysis across computingplatforms. Mol. Biol. Evol. 2018, 35, 1547–1549. [Google Scholar] [CrossRef]
- Trifinopoulos, J.; Nguyen, L.T.; von Haeseler, A.; Minh, B.Q. W-IQ-TREE: A fast online phylogenetic tool for maximum likelihood analysis. Nucleic Acids Res. 2016, 44, W232–W235. [Google Scholar] [CrossRef] [PubMed]
- Kalyaanamoorthy, S.; Minh, B.Q.; Wong, T.K.F.; Haeseler, A.V.; Jermiin, L.S. ModelFinder: Fast model selection for accurate phylogenetic estimates. Nat. Methods 2017, 14, 587–589. [Google Scholar] [CrossRef] [PubMed]
- Kusari, S.; Lamshöft, M.; Zühlke, S.; Spiteller, M. An endophytic fungus from Hypericum perforatum that produces hypericin. J. Nat. Prod. 2008, 71, 159–162. [Google Scholar] [CrossRef]
- Lagashetti, A.C.; Dufossé, L.; Singh, S.K.; Singh, P.N. Fungal pigments and their prospects in different industries. Microorganisms 2019, 7, 604. [Google Scholar] [CrossRef] [PubMed]
- Celestino, J.D.R.; Carvalho, L.E.; Lima, M.P.; Lima, A.M.; Ogusku, M.M.; Souza, J.V.B. Bioprospecting of Amazon soil fungi with the potential for pigment production. Process Biochem. 2014, 49, 569–575. [Google Scholar] [CrossRef]
- Da Costa Souza, P.N.; Grigoletto, T.L.B.; de Moraes, L.A.B.; Abreu, L.M.; Guimarães, L.H.S.; Santos, C.; Galvão, L.R.; Cardoso, P.G. Production and chemical characterization of pigments in filamentous fungi. Microbiology 2016, 162, 12–22. [Google Scholar] [CrossRef]
- Méndez, A.; Pérez, C.; Montañéz, J.C.; Martínez, G.; Aguilar, C.N. Red pigment production by Penicillium purpurogenum GH2 is influenced by pH and temperature. J. Zhejiang Univ. Sci. B 2011, 12, 961–968. [Google Scholar] [CrossRef]
- Bouhri, Y.; Askun, T.; Tunca, B.; Deniz, G.; Aksoy, S.A.; Mutlu, M. The orange-red pigment from Penicillium mallochii: Pigment production, optimization, and pigment efficacy against Glioblastoma cell lines. Biocatal. Agric. Biotechnol. 2020, 23, 101451. [Google Scholar] [CrossRef]
- Oliveira, L.A.; Macedo, M.M.; Rodrigues, J.L.S.; Lima, E.S.; Hamill, P.G.; Dallas, T.D.; Souza, J.V.B. Plant metabolite 5-pentadecyl resorcinol is produced by the Amazonian fungus Penicillium sclerotiorum LM 5679. Braz. J. Biol. 2021, 82, e241863. [Google Scholar] [CrossRef]
- Crous, P.W.; Slippers, B.; Wingfield, M.J.; Rheeder, J.; Marasas, W.F.O.; Phillips, A.J.L.; Alves, A.; Burgess, T.; Barber, P.; Groenewald, J.Z. Phylogenetic lineages in the Botryosphaeriaceae. Stud. Mycol. 2006, 55, 235–253. [Google Scholar] [CrossRef]
- Huang, S.-K.; Tangthirasunun, N.; Phillips, A.J.L.; Dai, D.-Q.; Wanasinghe, D.N.; Wen, T.-C.; Bahkali, A.H.; Hyde, K.D.; Kang, J.-C. Morphology and phylogeny of Neoscytalidium orchidacearum sp. nov. (Botryosphaeriaceae). Mycobiology 2016, 44, 79–84. [Google Scholar] [CrossRef]
- Dissanayake, A.J.; Phillips, A.J.L.; Hyde, K.D.; Yan, J.Y.; Li, X.H. The current status of species in Diaporthe. Mycosphere 2017, 8, 1106–1156. [Google Scholar] [CrossRef]
- Norphanphoun, C.; Gentekaki, E.; Hongsanan, S.; Jayawardena, R.; Manawasinghe, I.S.; Abeywickrama, P.D.; Bhunjun, C.S.; Hyde, K.D. Diaporthe: Formalizing the species-group concept. Mycosphere 2022, 13, 752–819. [Google Scholar] [CrossRef]
- Gomes, R.R.; Glienke, C.; Videira, S.I.R.; Lombard, L.; Groenewald, J.Z.; Crous, P.W. Diaporthe: A genus of endophytic, saprobic and plant pathogenic fungi. Persoonia 2013, 31, 1–41. [Google Scholar] [CrossRef] [PubMed]
- Iantas, J.; Savi, D.C.; Schibelbein, R.d.S.; Noriler, S.A.; Assad, B.M.; Dilarri, G.; Ferreira, H.; Rohr, J.; Thorson, J.S.; Shaaban, K.A.; et al. Endophytes of Brazilian medicinal plants with activity against phytopathogens. Front. Microbiol. 2021, 12, 714750. [Google Scholar] [CrossRef]
- Marin-Felix, Y.; Senwanna, C.; Cheewangkoon, R.; Crous, P.W. New species and records of Bipolaris and Curvularia from Thailand. Mycosphere 2017, 8, 1556–1574. [Google Scholar] [CrossRef]
- Sharma, D.; Gupta, C.; Aggarwal, S.; Nagpal, N. Pigment extraction from fungus for textile dyeing. Indian J. Fibre Text. Res. 2012, 37, 68–73. [Google Scholar]
- Caro, Y.; Venkatachalam, M.; Lebeau, J.; Fouillaud, M.; Dufossé, L. Pigments and colorants from filamentous fungi. In Fungal metabolites. Reference Series in Phytochemistry; Merillon, J.M., Ramawat, K., Eds.; Springer: Cham, Switzerland, 2016; pp. 499–568. [Google Scholar] [CrossRef]
- Kuhnert, E.; Navarro-Muñoz, J.C.; Becker, K.; Stadler, M.; Collemare, J.; Cox, R.J. Secondary metabolite biosynthetic diversity in the fungal family Hypoxylaceae and Xylaria hypoxylon. Stud. Mycol. 2021, 99, 100118. [Google Scholar] [CrossRef]
- Falcão, L.D.S.; Oliveira, I.D.L.; Gurgel, R.S.; de Souza, A.T.F.; Mendonça, L.D.S.; Usuda, É.O.; do Amaral, T.S.; Veggi, P.C.; Campelo, P.H.; de Vasconcellos, M.C.; et al. Development of cassava starch-based films incorporated with phenolic compounds produced by an Amazonian fungus. Int. J. Biol. Macromol. 2024, 258, 128882. [Google Scholar] [CrossRef]
- Aguirre, J.J.; De La Garza, T.H.; Zugasti, C.A.; Belmares, C.R.; Aguilar, C.N. The optimization of phenolic compounds extraction from cactus pear (Opuntia ficus-indica) skin in a reflux system using response surface methodology. Asian Pac. J. Trop. Biomed. 2013, 3, 436–442. [Google Scholar] [CrossRef]
- Gubiani, J.R.; Habeck, T.R.; Chapla, V.M.; Silva, G.H.; Bolzani, V.S.; Araujo, A.R. One strain-many compounds (OSMAC) method for production of phenolic compounds using Camarops sp., an endophytic fungus from Alibertia macrophylla (Rubiaceae). Quim. Nova 2016, 39, 1221–1224. [Google Scholar] [CrossRef]
- Dantas, S.B.S.; Moraes, G.K.A.; Araujo, A.R.; Chapla, V.M. Phenolic compounds and bioactive extract produced by endophytic fungus. Coriolopsis rigida. Nat. Prod. Res. 2022, 37, 2037–2042. [Google Scholar] [CrossRef] [PubMed]
- Oliveira, R.N.; Mancini, M.C.; de Oliveira, F.C.S.; Passos, T.M.; Quilty, B.; Thiré, R.M.D.S.M.; McGuinness, G.B. FTIR analysis and quantification of phenols and flavonoids of five commercially available plants extracts used in wound healing. Rev. Mater. 2016, 21, 767–779. [Google Scholar] [CrossRef]

| Locus 1 | Primer | Sequence 5′-3′ | T (°C) 2 | Reference |
|---|---|---|---|---|
| ITS | Its1 | TCCGTAGGTGAACCTGCGG | 62 | [37] |
| Its4 | TCCTCCGCTTATTGATATGC | |||
| tub2 | Bt-2a | GGT AAC CAA ATC GGT GCT GCT TTC | 62 | [38] |
| Bt-2b | ACC CTC AGT GTA GTG ACC CTT GGC | |||
| cal | CALM-228F | GAGTTCAAGGAGGCCTTCTCCC | 54 | [39] |
| CALM-737R | CATCTTTCTGGCCATCATGG | |||
| tef1 | EF1-728F | CAT CGA GAA GTT CGA GAA GG | 58 | [39] |
| EF1-986R | TAC TTG AAG GAA CCC TTA CC | |||
| rpb2 | RPB2-6F | TGG GGK WTG GTY TGY CCT GC | 58 | [40] |
| fRPB2-7cR | CCC ATR GCT TGY TTR CCC AT |
| λ (nm) | Endophytic Fungi from Fridericia chica | ||||||||
|---|---|---|---|---|---|---|---|---|---|
| CG2-7 | CF1-3 | CG2-4 | CG2-12 | CF1-37 | CG2-10 | CG2-5 | CG1-2 | CF3-5 | |
| 400 | 0 | 0 | 0 | 0 | 0 | 0 | 0 | 0 | 0 |
| 450 | 0 | 0 | 0 | 0 | 0 | 0 | 0 | 0 | 0 |
| 550 | 0 | 0.070 | 0 | 0 | 0 | 0 | 0.200 | 0 | 0 |
| 580 | 0 | 0.070 | 0 | 0 | 0 | 0 | 0.210 | 0 | 0 |
| 600 | 0 | 0.090 | 0 | 0 | 0 | 0 | 0.220 | 0 | 0 |
| 700 | 0 | 0.340 | 0.220 | 0.030 | 0 | 0.04 | 0.450 | 0 | 0.170 |
| Pigmented extract | ![]() | ![]() | ![]() | ![]() | ![]() | ![]() | ![]() | ![]() | ![]() |
| λ (nm) | Endophytic Fungi from Fridericia chica | ||||||||
|---|---|---|---|---|---|---|---|---|---|
| CG2-7 | CF1-3 | CG2-4 | CG2-12 | CF1-37 | CG2-10 | CG2-5 | CG1-2 | CF3-5 | |
| 400 | 0 | 0 | 0 | 0 | 0 | 1.96 | 1.74 | 0 | 0 |
| 450 | 0 | 0 | 0 | 0 | 0 | 0.610 | 0.330 | 0 | 0.110 |
| 550 | 0 | 0.020 | 0 | 0 | 0 | 0.930 | 0 | 0.530 | 0.150 |
| 580 | 0 | 0.030 | 0 | 0 | 0 | 0.950 | 0 | 0.530 | 0.130 |
| 600 | 0 | 0.040 | 0.020 | 0 | 0.480 | 0.940 | 0 | 0 | 0.140 |
| 700 | 0.120 | 0.300 | 0.260 | 0.120 | 0.550 | 1.22 | 0.040 | 0 | 0.380 |
| Pigmented extract | ![]() | ![]() | ![]() | ![]() | ![]() | ![]() | ![]() | ![]() | ![]() |
| Isolate | Species | Source | GenBank Accession Number | ||||
|---|---|---|---|---|---|---|---|
| ITS | tub2 | cal | tef1 | rpb2 | |||
| CF1-3 | Aspergillus sydowii | F. chica | OR799521 | OR805272 | OR805277 | - | OR805285 |
| CG2-7 | Aspergillus welwitschiae | F. chica | OR799615 | OR805273 | OR805278 | - | OR805286 |
| CF3-5 | Curvularia sp. | F. chica | OR799998 | - | - | - | OR805287 |
| CG2-4 | Diaporthe cerradensis | F. chica | OR800272 | - | OR805279 | OR805281 | - |
| CG2-12 | Diaporthe cerradensis | F. chica | OR800278 | - | OR805280 | OR805282 | - |
| CF1-37 | Hypoxylon investiens | F. chica | OR800289 | OR805274 | - | - | - |
| CG2-5 | Penicillium rubens | F. chica | - | OR805275 | - | - | OR805288 |
| CG1-2 | Neoscytalidium sp. | F. chica | OR800290 | - | - | OR805283 | - |
| CG2-10 | Neoscytalidium sp. | F. chica | OR800291 | OR805276 | - | OR805284 | - |
| Antioxidant Activity * | AA (%) | EC50 (μg/mL) | FRAP (µmol TE/g) | |||||||
|---|---|---|---|---|---|---|---|---|---|---|
| H. investiens CF1-37 extract | 91.08 | 780 | 105.54 | |||||||
| Quercetin | 98.00 | 8 | NT | |||||||
| Ascorbic acid | NT | NT | 163.10 | |||||||
| Antimicrobial Activity | MIC (mg/mL) | |||||||||
| EC | SM | PM | PA | BS | SA | KP | SE | CA | CT | |
| H. investiens CF1-37 extract | 5.00 | 5.00 | 2.50 | 1.25 | - | - | 2.50 | - | 2.50 | 2.50 |
Disclaimer/Publisher’s Note: The statements, opinions and data contained in all publications are solely those of the individual author(s) and contributor(s) and not of MDPI and/or the editor(s). MDPI and/or the editor(s) disclaim responsibility for any injury to people or property resulting from any ideas, methods, instructions or products referred to in the content. |
© 2024 by the authors. Licensee MDPI, Basel, Switzerland. This article is an open access article distributed under the terms and conditions of the Creative Commons Attribution (CC BY) license (https://creativecommons.org/licenses/by/4.0/).
Share and Cite
de Melo Pereira, D.Í.; Gurgel, R.S.; de Souza, A.T.F.; Matias, R.R.; de Souza Falcão, L.; Chaves, F.C.M.; da Silva, G.F.; Martínez, J.G.; de Lima Procópio, R.E.; Fantin, C.; et al. Isolation and Identification of Pigment-Producing Endophytic Fungi from the Amazonian Species Fridericia chica. J. Fungi 2024, 10, 77. https://doi.org/10.3390/jof10010077
de Melo Pereira DÍ, Gurgel RS, de Souza ATF, Matias RR, de Souza Falcão L, Chaves FCM, da Silva GF, Martínez JG, de Lima Procópio RE, Fantin C, et al. Isolation and Identification of Pigment-Producing Endophytic Fungi from the Amazonian Species Fridericia chica. Journal of Fungi. 2024; 10(1):77. https://doi.org/10.3390/jof10010077
Chicago/Turabian Stylede Melo Pereira, Dorothy Ívila, Raiana Silveira Gurgel, Anne Terezinha Fernandes de Souza, Rosiane Rodrigues Matias, Lucas de Souza Falcão, Francisco Celio Maia Chaves, Gilvan Ferreira da Silva, José Gregorio Martínez, Rudi Emerson de Lima Procópio, Cleiton Fantin, and et al. 2024. "Isolation and Identification of Pigment-Producing Endophytic Fungi from the Amazonian Species Fridericia chica" Journal of Fungi 10, no. 1: 77. https://doi.org/10.3390/jof10010077
APA Stylede Melo Pereira, D. Í., Gurgel, R. S., de Souza, A. T. F., Matias, R. R., de Souza Falcão, L., Chaves, F. C. M., da Silva, G. F., Martínez, J. G., de Lima Procópio, R. E., Fantin, C., & Albuquerque, P. M. (2024). Isolation and Identification of Pigment-Producing Endophytic Fungi from the Amazonian Species Fridericia chica. Journal of Fungi, 10(1), 77. https://doi.org/10.3390/jof10010077



















